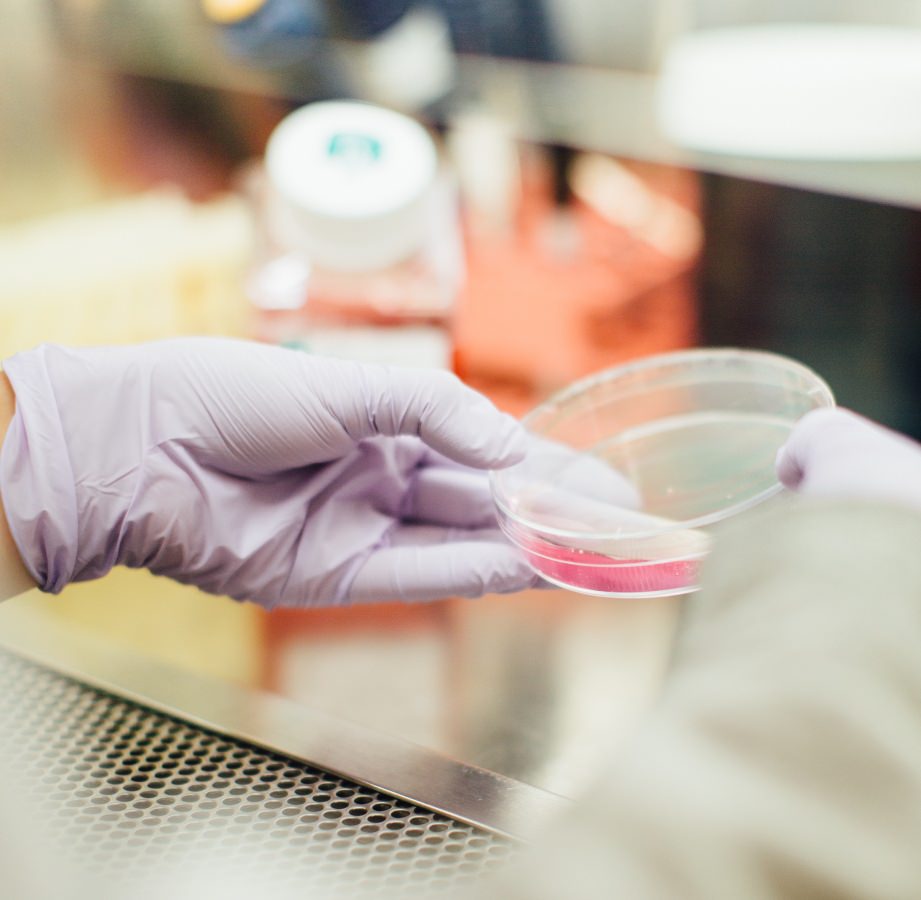
New Technology and Science Learning

How Good Is Our Sight?
What can we "make out?" Look at the photo of the flowers. Now look at just one blossom. You can see five petals. Back up and look Back away from the image of the blossom, as far as you can in the room or where ever you are. Can you still see the individual petals? But what if I make the photo image much smaller? At the distance you read a book, you can still see all five petals as individual petals. But start moving backward away from the image. What happens as you get 5

Dead Battery? What Not to Do!
What happened? Yesterday I planned to take the dog to a nearby dog park, but I would need to drive the car. So we prepared to go to the dog park, and when I tried to start the car, the battery was dead. I quickly discovered that I had left the headlights on the night before. So what do I do? The car is in the garage facing forward. So I cannot get a jumper-cable from another car, even if I could find someone to do it. So I called a neighbor who I knew, to see if she had a battery charger. She

At the Bottom of a Sea
We have no problem knowing that we are surrounded by air. We breathe it, and we feel the force of wind blowing against us when outside in a windstorm. Winds in storms can do great damage. Thus, the direct evidence that we are surrounded by air is something we experience. What are its properties? And what can it do? Let's Make An Interesting Observation I bought a 1-gallon metal can. After taking off the cap and pouring about 200 mL of water into the can, I placed it onto an electric stove h

Memory and Change—The Good, Bad, and Ugly: Part I
Here is a topic for which my blog title seems most appropriate, “Memory and Change.” How so much has changed over my lifetime—and how hard it is to remember. The acceleration of those changes has increasingly been most difficult to assimilate. And it does seem that one’s ability to adjust to change decreases as one ages. I am 86 years old, and even that objective fact is difficult to comprehend. What happened to me in these last 86 years? Where did they go? What did I do? How did the world chang
New Technology and Science Learning
Recently I talked with a 9th-grade high school student about her science class. She said it was an "online" biology course. I asked about the laboratory. She said there was no lab! Experience Before Terminology Perhaps the greatest violation of ample research evidence on how people learn science is the order in which terms are introduced in traditional instruction. First the term is given, then it is defined, often by using other unknown terms. Thus students are wrongly given terminology fi

Mariner Warning! Do What I Now Say, Not What I did!
Back in 1998, I bought a custom-built, 40 ft Ed Monk Trawler. This was my wonderful boat, Rainbow. This was a full-displacement vessel, with twin Lehman diesel engines, so it was very efficient. Most powerboats plane, and that requires a huge expenditure of fuel, but they are very fast. My trawler had a diesel generator so that we could have power whenever we were anchored and underway. When at a marina, we used its power. The trawler could do 1,100 miles on the 300 gallons of diesel fuel i

The Colors of Sunlight - How Do We Know?
How do you know that sunlight (ordinary "white light") contains the colors of the rainbow? Oh, you say, "Because the light in a rainbow comes from sunlight," or "I can make these colors with a prism." (This photo was taken from the stern of my trawler, aptly named Rainbow, in 2000.) But how do you know that the colors of the rainbow are not made by the water drops? Or by the glass in the prism? Sir Isaac Newton addressed this question long ago, in 1671/72. And why 1671/72? That is anothe